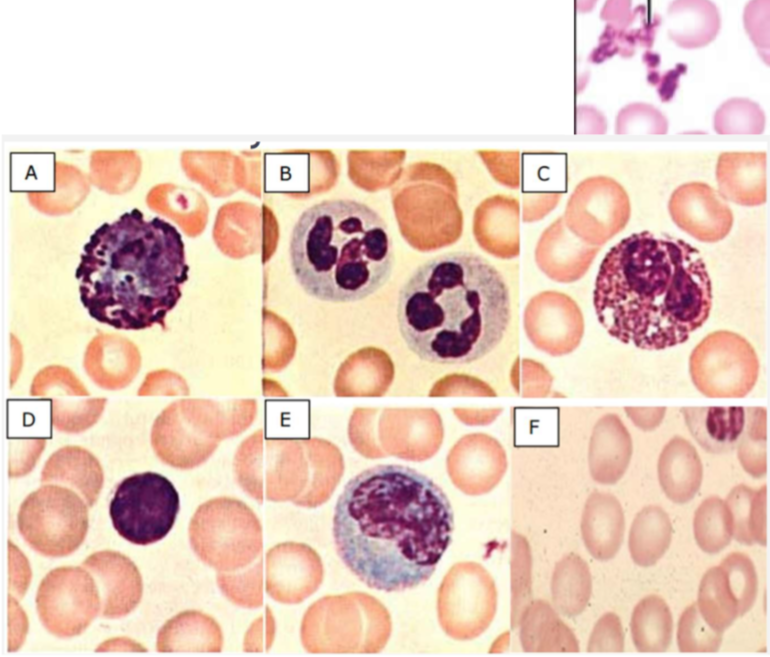

Most common stains, what they stain for
H+E
Composed of Haematoxylin and Eosin
Haematoxylin - stains nucleic acid/nucleus → BLUE
Eosin - stains proteins, collagen, fibrin, keratin → RED
Other stains
a) Trichome stain
b) Ziehl-Neelson stain
c) Elastin Ponceua stain
a) Stains collagen BLUE, muscle and fibrin strands RED
b) Stains TB bacteria PINK
c) Stains elastin BLACK (in the alveoli)
Identify A-F (and additional pic)
A - Basophil
B - Neutrophil
C - Eosinophil
D - Lymphocyte
E - Monocyte
F - RBCs
(G) - Platelets
Identify specimen and features A-D

Artery
A - Lumen of vessel
B - Tunica intima, endothelial cells (flat) and internal elastic lamina
C - Tunica media, vascular smooth muscle cells
D - Tunica adventitia, external elastic lamina and connective tissue (and blood vessels)

Identify tissue and features A-E

Uterus
A - Stroma, contains ‘supporting cells’ like fibroblasts, endothelial cells of blood vessels
B - luminal surface, lined by epithelial cells
C - lumen
D+E - Uterine gland (lined by epithelium)
Itentify specimen and features A-F

Uterine cervix
A - Stroma, the supporting connective tissue surrounding cervical glands
B - Columnar/glandular epithelium, lines ENDOCERVIX, a single layer of cells with nuclei at the basal aspect
C - Superficial cells, flatten to form squamous epithelial cell, mature cells exfoliate
D - Intermediate cells, large amount of glycogen (pale staining)
E - Supra-basal cells, basal layer mells migrate towards surface (no proliferation)
F - Basal proliferative layer, contains driving stem cells
Identify specimen and features A+B

Heart myocardium
A - Cardiomyocyte (seen longitudinally), nucleus in centre
B - Cardiomyocyte (seen in cross-section), nucelus in centre
Itentify specimen and features A-D

Lung
A - Small artery/arteriole, lined by endothelial cells (can’t see at this magnification)
B - Bronchiole, lined by mucosal epithelial cells (PURPLE)
C - Alveoli filled with air, very thin wall lined with epithelial cells and contains capillaries (can’t see at this magnification)
D - Collection of lymphocytes
Identify specimen and features A-F

Large intestine
A - Lumen
B - Goblet cell
C - Gland cut in cross section, opens into the lumen
D - Muscularis mucosae, thin strip of muscle supporting mucosal layer
E - Submucosa, outer serosal layer, lies beneath mucosa and the supporting muscularis mucosae
F - Base of the glands cut in cross section
Identify specimen and features A-E

Appendix
A - Patch of lymphocytes, found beneath mucosal layer (Mucosal Associated Lymphoid Tissue)
B - Muscularis propria, muscular layer that supports intestine, responsible for peristalsis, has circular and longitudinal layers
C - Serosa, outer surface facing peritoneum
D - Mucosal layer, can see pale droplets of mucin within goblet cells
E - Lumen of intestine
Identify specimen and features A+B

Liver
A - Central vein, blood leaves liver and re-enters circulation (another seen bottom right)
B - Sinusoid, blood flows into liver via portal vein from intestine and from hepatic artery, then flows through sinusoid into central vein
Identify specimen and features A-C

Kidney glomerulus
A - Glomerulus, formed from folded blood vessels
B+C - Renal tubule, lined with cuboidal epithelium
Identify specimen and features A+B

Thyroid
A - Colloid, pink-staining and gelatinous, precursor to thyroid hormones
B - Follicle, spherical layer of simple epithelial cells, lumen contains colloid. When cells stimulated by TSH, colloid taken up by the cells and converted to T3 and T4
Identify specimen and features A-C

Brain cerebrum
A - Grey matter, contains neuron bodies and supporting neuroglial cells
B - Blood vessel
C - White matter, contains nerve fibre tracts (cytoplasmic extensions of neurons) and supporting neuroglial cells


